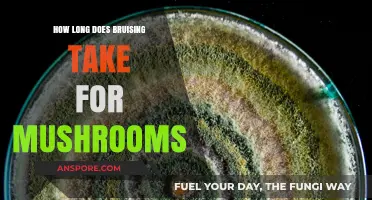
Understanding Mushroom Bruising: Healing Time and Factors Affecting Recovery

When it comes to storing cut mushrooms, understanding their shelf life is essential to maintain freshness and avoid spoilage. Once mushrooms are sliced or chopped, they begin to deteriorate more quickly due to increased exposure to air and moisture, which can lead to browning, sliminess, or mold growth. Generally, cut mushrooms can last in the refrigerator for about 1 to 2 days if stored properly in an airtight container or wrapped tightly in plastic wrap. To extend their lifespan, some recommend lightly coating them with lemon juice or vinegar to slow oxidation, though this may alter their flavor. For longer storage, freezing is an option, but it’s best to blanch or sauté them first to preserve texture and taste. Proper handling and storage are key to maximizing the freshness of cut mushrooms before they need to be discarded.
| Characteristics | Values |
|---|---|
| Refrigerator (Uncooked) | 1-2 days |
| Refrigerator (Cooked) | 3-4 days |
| Freezer | 10-12 months |
| Room Temperature | Not recommended, spoils quickly |
| Signs of Spoilage | Slimy texture, off odor, discoloration |
| Storage Tips | Store in paper bag or loosely wrapped in damp cloth in refrigerator |
Explore related products
$9.99 $11.99
What You'll Learn
- Storage Conditions: Refrigerator vs. pantry shelf life impact on cut mushrooms' freshness and longevity
- Preparation Methods: How slicing, dicing, or chopping affects mushroom spoilage rate
- Signs of Spoilage: Identifying discoloration, sliminess, or odor indicating cut mushrooms are bad
- Freezing Cut Mushrooms: Proper techniques to extend shelf life beyond refrigeration limits
- Health Risks: Consuming spoiled cut mushrooms: potential dangers and symptoms to watch for

Storage Conditions: Refrigerator vs. pantry shelf life impact on cut mushrooms' freshness and longevity
When it comes to storing cut mushrooms, the choice between the refrigerator and the pantry shelf significantly impacts their freshness and longevity. Cut mushrooms are more perishable than whole mushrooms because their exposed surfaces are prone to moisture loss and bacterial growth. The refrigerator is generally the best storage option for cut mushrooms, as it slows down the enzymatic processes and microbial activity that cause spoilage. When stored in the refrigerator, cut mushrooms can last for about 1 to 2 days if properly handled. To maximize their shelf life, place them in a breathable container, such as a paper bag or a loosely sealed plastic bag with a paper towel to absorb excess moisture. This helps maintain optimal humidity while preventing the mushrooms from becoming slimy or moldy.
In contrast, storing cut mushrooms on a pantry shelf is not recommended due to the lack of temperature control. Room temperature accelerates the deterioration process, causing mushrooms to spoil within a few hours to a day. The pantry environment is warmer and often more humid, which creates ideal conditions for bacteria and mold to thrive. Additionally, cut mushrooms left at room temperature are more likely to dry out or become mushy, rendering them unsuitable for consumption. Therefore, the pantry shelf is not a viable option for preserving the freshness and quality of cut mushrooms.
The refrigerator’s cool temperature, typically around 35°F to 40°F (2°C to 4°C), is crucial for extending the life of cut mushrooms. Cold temperatures slow down the metabolic activities of microorganisms and enzymes, delaying spoilage. However, even in the refrigerator, cut mushrooms have a limited lifespan due to their increased susceptibility to degradation. It’s essential to use them as quickly as possible or consider preserving methods like freezing or drying if you cannot consume them within the recommended timeframe. Freezing, for instance, can extend their usability to several months, though it may alter their texture, making them better suited for cooked dishes rather than raw applications.
Another factor to consider is the initial quality of the mushrooms before cutting. Fresh, firm mushrooms with no signs of spoilage will last longer than those that are already soft or discolored. Properly cleaning and handling mushrooms before storage also plays a role in their longevity. Avoid washing cut mushrooms until you’re ready to use them, as excess moisture can hasten decay. Instead, gently brush off dirt or wipe them with a damp cloth before storing. These practices, combined with proper refrigeration, ensure that cut mushrooms retain their freshness for as long as possible.
In summary, the refrigerator is the optimal storage condition for cut mushrooms, offering a shelf life of 1 to 2 days when stored correctly. The pantry shelf, on the other hand, drastically reduces their freshness and longevity, making it an unsuitable option. By understanding the impact of storage conditions and following best practices, you can minimize waste and enjoy cut mushrooms at their best. Always prioritize quick usage or alternative preservation methods if refrigeration is not feasible.
Perfect Shiitake Soak Time: Mastering Dried Mushroom Rehydration
You may want to see also

Preparation Methods: How slicing, dicing, or chopping affects mushroom spoilage rate
When it comes to the longevity of cut mushrooms, the preparation method plays a significant role in determining how quickly they spoil. Slicing, dicing, or chopping mushrooms increases their surface area, exposing more of the mushroom’s flesh to air, moisture, and microorganisms. This exposure accelerates the enzymatic browning process and creates more entry points for bacteria and mold, ultimately shortening their shelf life. Understanding how each cutting technique affects spoilage can help you maximize freshness and minimize waste.
Slicing Mushrooms: Slicing mushrooms into larger pieces exposes a moderate amount of surface area compared to dicing or chopping. Thicker slices retain moisture better than smaller cuts, which can slow down the drying process. However, the increased surface area still makes sliced mushrooms more susceptible to browning and microbial growth than whole mushrooms. To extend their life, store sliced mushrooms in an airtight container lined with a paper towel to absorb excess moisture, and use them within 2–3 days for optimal freshness.
Dicing Mushrooms: Dicing mushrooms into small, uniform cubes significantly increases their surface area, making them more prone to rapid spoilage. The smaller pieces dry out faster and are more vulnerable to enzymatic browning and microbial contamination. Diced mushrooms should be used within 1–2 days to avoid texture degradation and off-flavors. Storing them in a humid environment, such as a sealed container with a damp paper towel, can help retain moisture and delay spoilage, but this method is less effective compared to larger cuts.
Chopping Mushrooms: Chopping mushrooms into irregular, coarse pieces exposes a surface area similar to dicing but with less uniformity. This method can lead to uneven drying and browning, as some pieces may be smaller and more exposed than others. Chopped mushrooms typically last 2–3 days when stored properly, but their irregular size can make them less ideal for recipes requiring consistent texture. To mitigate spoilage, store chopped mushrooms in the refrigerator with minimal air exposure and use them promptly in cooked dishes.
Minimizing Spoilage Across Methods: Regardless of the cutting technique, proper storage is key to extending the life of cut mushrooms. Always store them in the refrigerator, as room temperature accelerates spoilage. Use airtight containers or resealable bags to limit oxygen exposure, and consider adding a paper towel to absorb excess moisture. For longer storage, blanching or sautéing cut mushrooms before refrigeration can deactivate enzymes responsible for browning and kill surface microorganisms, extending their life by a few additional days. However, this method alters their texture and flavor, making it best suited for mushrooms intended for cooking rather than raw use.
In summary, the smaller the cut, the faster mushrooms spoil due to increased surface area exposure. Slicing offers a balance between usability and longevity, while dicing and chopping demand quicker consumption. By choosing the appropriate preparation method and employing proper storage techniques, you can enjoy cut mushrooms at their freshest for as long as possible.
Perfectly Cooked Sliced Mushrooms: Timing Tips for Tender Results
You may want to see also

Signs of Spoilage: Identifying discoloration, sliminess, or odor indicating cut mushrooms are bad
When determining if cut mushrooms have gone bad, one of the first signs to look for is discoloration. Freshly cut mushrooms typically have a uniform light brown or white color, depending on the variety. As they spoil, you may notice dark spots or patches developing on the surface. These spots can range from brown to black and often indicate the growth of mold or the breakdown of the mushroom’s cell structure. If you see widespread discoloration or a significant change in color, it’s a clear sign that the mushrooms are no longer safe to eat.
Another critical indicator of spoilage in cut mushrooms is sliminess. Fresh mushrooms should feel slightly moist but not wet or slippery. If you notice a slimy texture on the surface of the mushrooms, it’s a sign that bacteria or mold have begun to grow. This sliminess is often accompanied by a breakdown in the mushroom’s firm texture, making them feel mushy or soft to the touch. Once sliminess appears, the mushrooms have likely passed their prime and should be discarded.
Odor is another key factor in identifying spoiled cut mushrooms. Fresh mushrooms have a mild, earthy scent that is pleasant and not overpowering. As they begin to spoil, they may develop a sharp, ammonia-like smell or a sour, off-putting odor. This unpleasant smell is a result of bacterial activity and the release of volatile compounds as the mushrooms decompose. If you detect any foul or unusual odors, it’s a strong indication that the mushrooms are bad and should not be consumed.
In addition to these signs, mold growth is a definitive indicator that cut mushrooms have spoiled. Mold can appear as fuzzy patches of green, white, or black on the surface of the mushrooms. While some molds are harmless, others can produce toxins that are dangerous if ingested. Even if mold is only visible in small areas, it’s best to discard the entire batch, as mold spores can spread quickly and invisibly throughout the mushrooms.
Lastly, texture changes can also signal spoilage in cut mushrooms. Fresh mushrooms should be firm and slightly spongy. If they become excessively soft, mushy, or watery, it’s a sign that they are breaking down and spoiling. This texture change often accompanies the other signs of spoilage, such as discoloration and sliminess. When in doubt, trust your senses—if the mushrooms look, feel, or smell off, it’s safer to err on the side of caution and dispose of them.
When to Expect Oyster Mushrooms: Timing Your Log's First Fruiting
You may want to see also
Explore related products

Freezing Cut Mushrooms: Proper techniques to extend shelf life beyond refrigeration limits
Freezing cut mushrooms is an excellent method to extend their shelf life significantly beyond what refrigeration can offer. When stored in the refrigerator, cut mushrooms typically last only 1 to 2 days due to their high moisture content and susceptibility to spoilage. However, when frozen correctly, they can retain their quality for up to 12 months. The key to successful freezing lies in preparing the mushrooms properly before they go into the freezer. Start by selecting fresh, firm mushrooms and clean them gently with a damp cloth or brush to remove dirt. Avoid washing them in water, as excess moisture can lead to ice crystals forming during freezing, which degrades their texture.
Once cleaned, slice or chop the mushrooms according to your intended use. Blanching is a crucial step in the freezing process, as it helps preserve color, texture, and flavor. To blanch mushrooms, bring a pot of water to a boil and submerge the cut mushrooms for 1 to 2 minutes. Immediately transfer them to a bowl of ice water to halt the cooking process. Blanching also helps destroy enzymes that can cause spoilage over time. After blanching, drain the mushrooms thoroughly and pat them dry with a clean kitchen towel or paper towels to remove as much moisture as possible.
After preparing the mushrooms, it’s essential to package them correctly to prevent freezer burn and maintain their quality. Use airtight containers, freezer-safe bags, or vacuum-sealed bags to store the mushrooms. If using bags, press out as much air as possible before sealing. For added convenience, consider portioning the mushrooms into recipe-sized amounts before freezing, so you can easily grab what you need without thawing the entire batch. Label the containers or bags with the date of freezing to keep track of their storage time.
Another effective technique is to freeze mushrooms on a tray before transferring them to storage containers. Spread the blanched and dried mushrooms in a single layer on a baking sheet lined with parchment paper and place it in the freezer. Once the mushrooms are frozen solid (usually after 1 to 2 hours), transfer them to airtight containers or bags. This method, known as flash freezing, prevents the mushrooms from clumping together, making it easier to measure out specific quantities when needed.
When ready to use the frozen mushrooms, there’s no need to thaw them first. Simply add them directly to soups, stews, stir-fries, or sauté pans, and they will cook quickly while retaining their flavor and texture. Keep in mind that frozen mushrooms are best used in cooked dishes rather than raw applications, as the freezing process alters their texture slightly. By following these proper techniques for freezing cut mushrooms, you can enjoy their versatility and nutritional benefits long after their typical refrigeration period has passed.
Perfect Risotto: Optimal Soaking Time for Dried Mushrooms Revealed
You may want to see also

Health Risks: Consuming spoiled cut mushrooms: potential dangers and symptoms to watch for
Consuming spoiled cut mushrooms can pose significant health risks, as they may harbor harmful bacteria, molds, or toxins that develop as the mushrooms degrade. Unlike whole mushrooms, cut mushrooms have exposed surfaces that allow bacteria and mold to grow more rapidly, especially when stored improperly. The primary danger lies in the potential for foodborne illnesses caused by pathogens such as *Salmonella*, *E. coli*, or *Listeria*. These bacteria thrive in moist environments and can multiply quickly on cut mushrooms left at room temperature or stored for too long, even in the refrigerator. Ingesting these pathogens can lead to severe gastrointestinal symptoms, including nausea, vomiting, diarrhea, and abdominal pain, which may appear within hours or days after consumption.
Another health risk associated with spoiled cut mushrooms is the presence of mycotoxins produced by molds. While not all molds are toxic, certain strains can produce harmful substances that are not destroyed by cooking. Mycotoxin exposure can cause symptoms ranging from mild allergic reactions, such as itching and swelling, to more severe conditions like respiratory distress or organ damage in extreme cases. Individuals with weakened immune systems, pregnant women, and young children are particularly vulnerable to these toxins. It is crucial to inspect cut mushrooms for visible mold growth, sliminess, or off-odors before consumption, as these are clear indicators of spoilage.
In addition to bacterial and mold-related risks, spoiled cut mushrooms may also undergo chemical changes that render them unsafe to eat. As mushrooms decompose, they release enzymes that break down their cellular structure, leading to a mushy texture and unpleasant taste. While this process itself is not always harmful, it often coincides with the growth of pathogens or toxins. Consuming such mushrooms can result in food poisoning, characterized by symptoms like fever, chills, and dehydration. Prolonged or severe cases may require medical attention, especially if symptoms persist or worsen over time.
To minimize health risks, it is essential to adhere to proper storage guidelines for cut mushrooms. They should be stored in the refrigerator in a breathable container, such as a paper bag or loosely wrapped in a paper towel, and consumed within 1-2 days of cutting. If stored in an airtight container or left at room temperature, spoilage can occur much faster. Always trust your senses—if cut mushrooms appear slimy, discolored, or emit a foul odor, discard them immediately. By being vigilant and informed, you can avoid the potential dangers of consuming spoiled cut mushrooms and protect your health.
Perfectly Cooked Stuffed Portabella Mushrooms: Timing Tips for Delicious Results
You may want to see also
Frequently asked questions
Cut mushrooms can last in the fridge for 1 to 2 days if stored properly in an airtight container or wrapped in plastic wrap.
Yes, cut mushrooms can be frozen for up to 10–12 months. Blanch them briefly or sauté before freezing for best results.
Cut mushrooms have gone bad if they develop a slimy texture, darken significantly, or have a strong, unpleasant odor.
Avoid storing cut mushrooms in water, as they can become soggy. Instead, place them in a paper bag or wrap them loosely in a damp paper towel before refrigerating.
It’s best to discard cut mushrooms after 2 days in the fridge, as they may start to spoil and lose their texture and flavor.